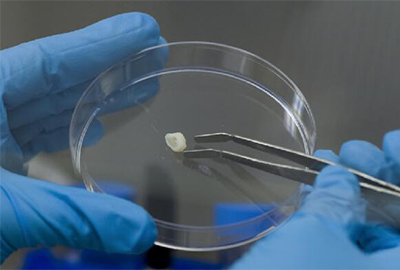
小孩牙周炎自愈的最佳方法,儿童牙周炎能治好吗

俗话说,“病从口入”,“吃嘛嘛香”,牙齿的健康与全身健康密切相关。我们自己或者身边的亲戚朋友,经常会出现牙疼、牙龈红肿、牙龈出血、牙齿松动的情况,几乎都误以为是“上火”造成的。但实际上,这些都是慢性牙周炎的体现。


据相关报道显示,牙周炎与细菌性心内膜炎、血栓、慢性阻塞性肺气肿的发生密切相关。牙周炎和慢性阻塞性肺气肿的症状可以相互影响,甚至加重。牙周炎危害如此之大,但是治疗牙周炎的方法却很有限,我们熟悉的刮治、洗牙等,都只停留在牙齿表面。而乳牙干细胞治疗牙周炎则打破了这一僵局,为牙周炎痊愈带来了新希望。
专家表示:“乳牙干细胞治疗牙周炎是指:取出牙齿中的干细胞,经过体外培养、扩增后,再将干细胞注入有牙周炎的牙齿周围组织。乳牙干细胞可以消减牙周炎症,使局部组织的再生能力恢复,长出新组织,并帮助局部微环境再平衡,从而治疗牙周炎。”


牙齿中的干细胞
近百年来的干细胞发展,科学家已经在人体中发现了间充质干细胞,间充质干细胞作为一类无伦理争议、无配型麻烦、遍布人体广泛的干细胞而受到科研人员的青睐。
2000年,宾夕法尼亚大学教授在儿童乳牙中发现了间充质干细胞的存在,并在随后的研究中发现,乳牙中含有的同类细胞具有更高的活性,提取也更为简单,这就是乳牙干细胞。
实验证明乳牙中提取的干细胞对颅颌面骨再生、治疗牙周炎,SLE(系统性红斑狼疮)、糖尿病、硬皮病等各种免疫性疾病都具有很好的治疗效果。因此,日本、美国、中国等国先后建立乳牙干细胞储存机构,为国民健康提供保障。





